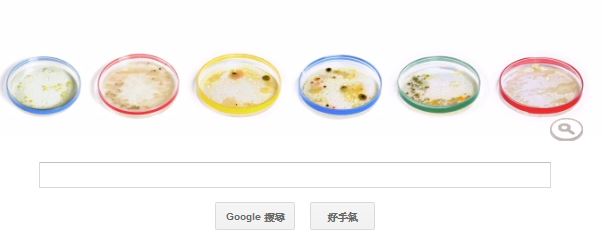

還記得學生時代做實驗時,會使用一個玻璃小圓盤,來培養一些微生物與小型植物,這小圓盤由一個平面圓盤狀的底和一個蓋組成,英文稱他為Petri dish,而名字由來與今天的Google Doodle很有關係。
今天的Google Doodle就是由剛剛所說的Petri dish 培養皿所構成,而2013年5月31日就是培養皿的發明人Julius Richard Petri 160歲誕辰紀念,而培養皿就是以他的姓作為命名。
Julius Richard Petri 於1852年5月31日的德國出生,他一開始在Kaiser-Wilhelm-Academy for Military Physicians (1871–1875) 學習醫學,並於1876年拿到學位。後來又在柏林的Charité Hospital繼續研究,直到1882年開始從事軍醫工作。而這個生物學與醫學很重要的實驗器具 培養皿,就是在1887所設計發明。

一般來說培養皿使用前都必須滅菌消毒,大多利用高溫高壓來進行,由於有了Petri dish的設計,可讓醫學與生物學可以有更方便的實驗器具可使用,在發明人Julius Richard Petri 160歲誕辰的這一天,我們一起來緬懷他。
想要知道更多更快的科技訊息嗎?還不快加入Kisplay科技快報!
其他推薦文章




